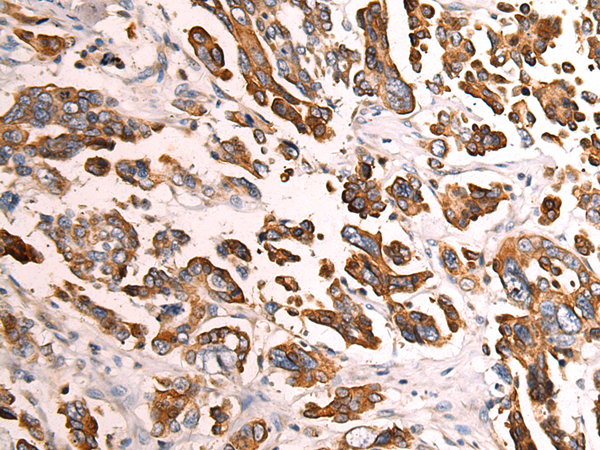

-
分类: 科研抗体货号: P09955别名:应用: WB反应种属: Human
-
分类: 科研抗体货号: P09971别名: MFDM; MFDGA; Snu114; Snrp116; SNRNP116; U5-116KD应用: WB,IHC反应种属: Human, Mouse
-
分类: 科研抗体货号: P09980别名: TF2A2; TFIIA; T18745; TFIIAS; HsT18745; TFIIA-12; TFIIA-gamma应用: IHC反应种属: Human, Mouse, Rat
-
分类: 科研抗体货号: P09970别名: INPP4; TVAS1应用: IHC反应种属: Human, Mouse, Rat
-
分类: 科研抗体货号: P09979别名: ROC1; RNF75; BA554C12.1应用: IHC反应种属: Human, Mouse
-
分类: 科研抗体货号: P09978别名: FKBP1; PKC12; PKCI2; FKBP12; PPIASE; FKBP-12; FKBP-1A应用: WB,IHC反应种属: Human, Mouse, Rat
-
分类: 科研抗体货号: P09969别名: NID-2应用: IHC反应种属: Human, Mouse, Rat
-
分类: 科研抗体货号: P09977别名: ERP1; Z1971应用: IHC反应种属: Human
-
分类: 科研抗体货号: P09968别名: Mrd1应用: IHC反应种属: Human, Mouse
-
分类: 科研抗体货号: P09995别名: H3.3B; H3F3B应用: WB,IHC反应种属: Human, Mouse, Rat

鄂公网安备42018502007531号
鄂公网安备42018502007531号

